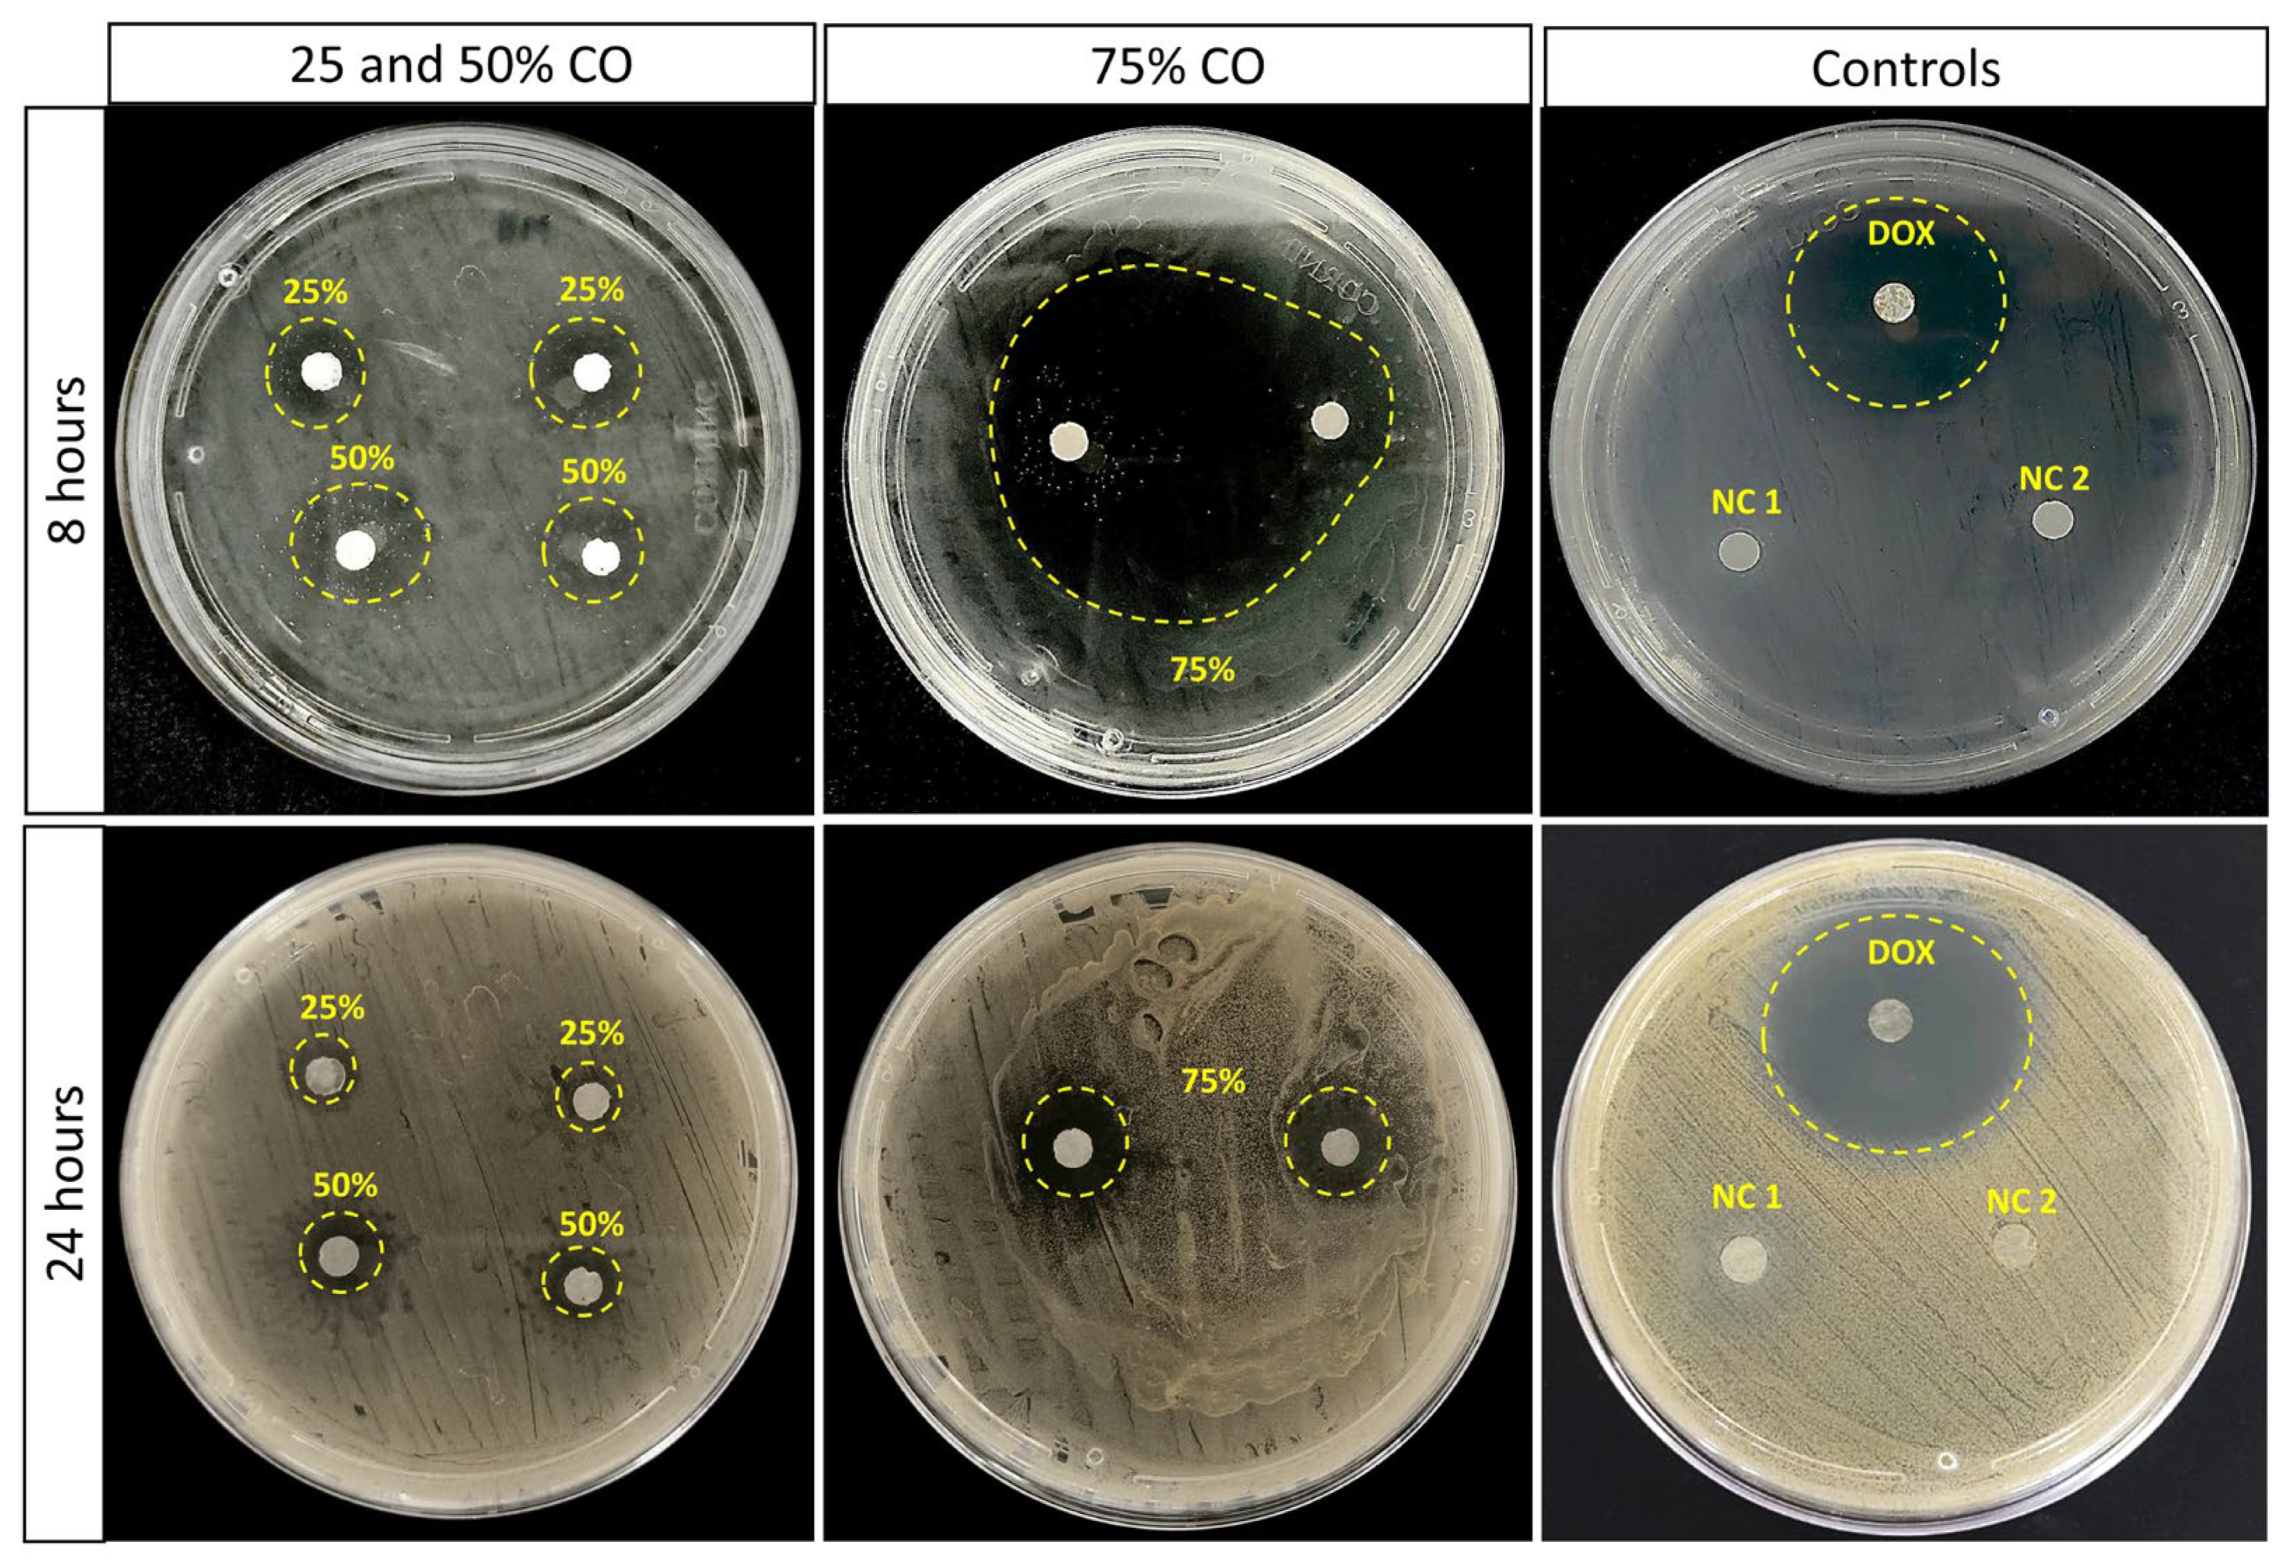
Antibiotics 12 00898 g002

Electrospun Membrane Based on Poly(L-co-D,L lactic acid) and Natural Rubber Containing Copaiba Oil Designed as a Dressing with Antimicrobial Properties
Abstract
:1. Introduction
2. Results
2.1. Fourier-Transform Infrared Spectroscopy
2.2. In Vitro Antimicrobial Activity
2.3. Zeta Potential Measurement
2.4. Biofilm Formation through SEM
2.5. Crystal Violet Assay
2.6. Oil Copaiba Release Test
3. Discussion
4. Materials and Methods
4.1. Membrane Preparation
4.2. Characterization
4.2.1. Fourier-Transform Infrared Spectroscopy
4.2.2. In Vitro Antimicrobial Activity
Bacteria Preparation
Antibiogram Assay
4.2.3. Zeta Potential Measurement
4.2.4. Biofilm Formation via SEM
4.2.5. Biofilm Formation via Crystal Violet Assay
4.2.6. Oil Copaiba Release Test
4.2.7. PBS Swelling Test
5. Conclusions
Author Contributions
Funding
Institutional Review Board Statement
Informed Consent Statement
Data Availability Statement
Acknowledgments
Conflicts of Interest
References
- Shamim, A.; Ali, A.; Iqbal, Z.; Mirza, M.A.; Aqil, M.; Kawish, S.M.; Siddiqui, A.; Kumar, V.; Naseef, P.P.; Alshadidi, A.A.F.; et al. Natural Medicine a Promising Candidate in Combating Microbial Biofilm. Antibiotics 2023, 12, 299. [Google Scholar] [CrossRef]
- Pinto, E.P.; Menezes, R.P.; Tavares, W.S.; Ferreira, A.M.; Sousa, F.F.O.; Silva, G.A.; Zamora, R.R.M.; Araújo, R.S.; Souza, T.M. Copaiba essential oil loaded-nanocapsules film as a potential candidate for treating skin disorders: Preparation, characterization, and antibacterial properties. Int. J. Pharm. 2023, 633, 122608. [Google Scholar] [CrossRef]
- Luraghi, A.; Peri, F.; Moroni, L. Electrospinning for drug delivery applications: A review. J. Control. Release 2021, 334, 463–484. [Google Scholar] [CrossRef]
- Adeosum, S.O.; Ilomuanya, M.O.; Gbenebor, O.P.; Dada, M.O.; Odili, C.C. Biomaterial for Drug Delivery: Sources, Classification, Synthesis, Processing, and Applications. In Advanced Functional Materials; InTechOpen: London, UK, 2020; pp. 141–167. [Google Scholar] [CrossRef]
- Tang, Y.; Varyambath, A.; Ding, Y.; Chen, B.; Huang, X.; Zhang, Y.; Yu, D.-G.; Kim, I.; Song, W. Porous organic polymers for drug delivery: Hierarchical pore structures, variable morphologies, and biological properties. Biomater. Sci. 2022, 10, 5369. [Google Scholar] [CrossRef]
- Pillay, V.; Dott, C.; Choonara, Y.E.; Tyagi, C.; Tomar, L.; Kumar, P.; Toit, L.C.; Ndesendo, V.M.K. A Review of the Effect of Processing Variables on the Fabrication of Electrospun Nanofibers for Drug Delivery Applications. J. Nanomater. 2013, 2013, 789289. [Google Scholar] [CrossRef]
- Guo, S.; Jiang, W.; Shen, L.; Zhang, G.; Gao, Y.; Yang, Y.; Yu, D.-G. Electrospun Hybrid Films for Fast and Convenient Delivery of Active Herb Extracts. Membranes 2022, 12, 398. [Google Scholar] [CrossRef]
- Sequeira, R.S.; Miguel, S.P.; Cabral, C.S.D.; Moreira, A.F.; Ferreira, P.; Correia, I.J. Development of a poly(vinyl alcohol)/lysine electrospun membrane-based drug delivery system for improved skin regeneration. Int. J. Pharm. 2019, 570, 118640. [Google Scholar] [CrossRef]
- Miguel, S.P.; Simões, D.; Moreira, A.F.; Sequeira, R.S.; Correia, I.J. Production and characterization of electrospun silk fibroin based asymmetric membranes for wound dressing applications. Int. J. Biol. Macromol. 2019, 121, 524–535. [Google Scholar] [CrossRef]
- Ahmadi, S.; Hivechi, A.; Bahrami, S.H.; Milan, P.B.; Ashraf, S.S. Cinnamon extract loaded electrospun chitosan/gelatin membrane with antibacterial activity. Int. J. Biol. Macromol. 2021, 173, 580–590. [Google Scholar] [CrossRef]
- Adamu, B.F.; Gao, J.; Jhatial, A.K.; Kumelachew, D.M. A review of medicinal plant-based bioactive electrospun nano fibrous wound dressings. Mater. Des. 2021, 209, 109942. [Google Scholar] [CrossRef]
- Rodrigues, V.M.; Oliveira, W.N.; Pereira, D.T.; Alencar, É.N.; Porto, D.L.; Aragão, C.F.S.; Moreira, S.M.G.; Rocha, H.A.O.; Machado, L.A.; Egito, E.S.T. Copaiba Oil-Loaded Polymeric Nanocapsules: Production and In Vitro Biosafety Evaluation on Lung Cells as a Pre-Formulation Step to Produce Phytotherapeutic Medicine. Pharmaceutics 2023, 15, 161. [Google Scholar] [CrossRef]
- Santos, A.O.; Nakamura, T.U.; Dias Filho, B.P.; Veiga Junior, V.F.; Pinto, A.C.; Nakamura, C.V. Antimicrobial Activity of Brazilian Copaiba Oils Obtained from Different Species of the Copaifera genus. Mem. Inst. Oswaldo Cruz 2008, 3, 103. [Google Scholar] [CrossRef]
- Pieri, F.A.; Mussi, M.C.M.; Fiorini, J.E.; Moreira, M.A.S.; Schneedorf, J.M. Bacteriostatic Effect of Copaiba Oil (Copaifera officinalis) Against Streptococcus mutans. Braz. Dent. J. 2012, 23, 36–38. [Google Scholar] [CrossRef]
- Pascoal, D.R.C.; Cabral-Abulquerque, E.C.M.; Veloso, E.S.; Souza, H.C.; Melo, S.A.B.V.; Braga, M.E.M. Copaiba oil-loaded commercial wound dressings using supercritical CO2: A potential alternative topical antileishmanial treatment. J. Supercrit. Fluids 2017, 129, 106–115. [Google Scholar] [CrossRef]
- Liu, Y.; Li, K.; Mohideen, M.M.; Ramakrishna, S. Development of melt electrospinning. Melt Electrospinn. 2019, 1–5. [Google Scholar] [CrossRef]
- Ramalingam, R.; Dhand, C.; Leung, C.M.; Ezhilarasu, H.; Prasannan, P.; Ong, S.T.; Subramanian, S.; Kamruddin, M.; Lakshminarayanan, R.; Ramakrishna, S.; et al. Poly-ε-Caprolactone/Gelatin Hybrid Electrospun Composite Nanofibrous Mats Containing Ultrasound Assisted Herbal Extract: Antimicrobial and Cell Proliferation Study. Nanomaterials 2019, 9, 462. [Google Scholar] [CrossRef]
- Jassal, M.; Sangupta, S.; Bhowmick, S. Functionalization of Electrospun Poly(caprolactone) Fibers for pH-controlled Delivery of Doxorubicin Hydrochloride. J. Biomater. Sci. Polym. Ed. 2015, 26, 1425–1438. [Google Scholar] [CrossRef]
- Leal, C.V.; Almeida, R.S.; Dávila, J.L.; Domingues, J.A.; Hausen, M.A.; Duek, E.A.R.; d’Ávila, M.A. Characterization and in vitro evaluation of electrospun aligned-fiber membranes of poly (L-co-D,L-lactic acid). J. Appl. Polym. Sci. 2019, 136, 47657. [Google Scholar] [CrossRef]
- Guerra, N.B.; Pegorin, G.S.A.; Boratto, M.H.; de Barros, N.R.; de Oliveira Graeff, C.F.; Herculano, R.D. Biomedical applications of natural rubber latex from the rubber tree Hevea brasiliensis. Mater. Sci. Eng. C 2021, 126, 112126. [Google Scholar] [CrossRef]
- Norcino, L.B.; Mendes, J.F.; Natarelli, C.V.L.; Marinch, A.; Oliveira, J.E.; Mattoso, L.H.C. Pectin films loaded with copaiba oil nanoemulsions for potential use as bio-based active packaging. Food Hydrocoll. 2020, 106, 105862. [Google Scholar] [CrossRef]
- Guerra, N.B.; Cassel, J.B.; Henckes, N.A.C.; Oliveira, F.S.; Lima, E.O.C.; Santos, L.A.L. Chemical and in vitro characterization of epoxidized natural rubber blends for biomedical applications. J. Polym. Res. 2018, 25, 172. [Google Scholar] [CrossRef]
- Tobouti, P.L.; Martins, T.C.A.; Pereira, T.J.; Mussi, M.C.M. Antimicrobial activity of copaiba oil: A review and a call for further research. Biomed. Pharmacother. 2017, 94, 93–99. [Google Scholar] [CrossRef]
- Mainardes, R.M.; Khalil, N.M.; Gremião, M.P.D. Intranasal delivery of zidovudine by PLA and PLA–PEG blend nanoparticles. Int. J. Pharm. 2010, 395, 266–271. [Google Scholar] [CrossRef]
- Ariyawiriyanan, W.; Nuinu, J.; Sae-Heng, K.; Kawahara, S. The mechanical properties of vulcanized deproteinized natural rubber. Energy Procedia 2013, 34, 728–733. [Google Scholar] [CrossRef]
- Medvedova, A.; Valík, Ľ. Staphylococcus Aureus: Characterisation and Quantitative Growth Description in Milk and Artisanal Raw Milk Cheese Production. In Structure and Function of Food Engineering; InTechOpen: London, UK, 2012; pp. 71–102. [Google Scholar] [CrossRef]
- Shukla, S.K.; Rao, T.S. An Improved Crystal Violet for biofilm quantification in 96-well microtitre plate. bioRxiv 2017. [Google Scholar] [CrossRef]
- Ardekani-Zadeh, A.H.; Hosseini, S.F. Electrospun essential oil-doped chitosan/poly (ε-caprolactone) hybrid nanofibrous mats for antimicrobial food biopackaging exploits. Carbohydr. Polym. 2019, 223, 115108. [Google Scholar] [CrossRef]
- Scaffaro, R.; Botta, L.; Maio, A.; Gallo, G. PLA graphene nanoplatelets nanocomposites: Physical properties and release kinetics of an antimicrobial agent. Compos. Part B Eng. 2017, 109, 138–146. [Google Scholar] [CrossRef]
- López-Muñoz, R.; López, R.G.; Saade, H.; Licea-Claverie, A.; Enríquez-Medrano, F.J.; Morales, G.; Grande, D. Preparation and release behavior of poly (methyl methacrylate-co-methacrylic acid)-based electrospun nanofibrous mats loaded with doxorubicin. Polym. Bull. 2022, 79, 1–20. [Google Scholar] [CrossRef]
- Hermosilla, J.; Pastene-Navarrete, E.; Acevedo, F. Electrospun fibers loaded with natural bioactive compounds as a biomedical system for skin burn treatment: A Review. Pharmaceutics 2021, 13, 2054. [Google Scholar] [CrossRef]
- Farhaj, S.; Conway, B.R.; Ghori, M.U. Nanofibres in Drug Delivery Applications. Fibers 2023, 11, 21. [Google Scholar] [CrossRef]
- Rodrigues, G.M.; Filgueiras, C.T.; Garcia, V.A.S.; Carvalho, R.A.; Velasco, J.I.; Fackouri, F.M. Antimicrobial activity and gc-ms profile of copaiba oil for incorporation into Xanthosoma mafaffa schott starch-based films. Polymers 2020, 12, 2883. [Google Scholar] [CrossRef]
- Masson, D.S.; Salvador, S.L.; Polizello, A.C.M.; Frade, M.A.C. Antimicrobial activity of copaíba (Copaifera langsdorffii) oleoresin on bacteria of clinical significance in cutaneous wounds. Rev. Bras. Plantas Med. 2013, 15, 664–669. [Google Scholar] [CrossRef]
- Zhao, R.; Li, X.; Sun, B.; Zhang, Y.; Zhang, D.; Tang, Z.; Zhen, X.; Wang, C. Electrospun chitosan/sericin composite nanofibers with antibacterial property as potential wound dressings. Int. J. Biol. Macromol. 2014, 68, 92–97. [Google Scholar] [CrossRef]
- Pompa-Monroy, D.A.; Figueroa-Marchant, P.G.; Dastager, S.G.; Thorat, M.N.; Iglesias, A.L.; Miranda-Soto, V.; Villarreal-Gómez, L.J. Bacterial biofilm formation using pcl/curcumin electrospun fibers and its potential use for biotechnological applications. Materials 2020, 13, 5556. [Google Scholar] [CrossRef]
- Guimarães, A.L.; Cunha, E.A.; Matias, F.O.; Garcia, P.G.; Danopoulos, P.; Swikidisa, R.; Pinheiro, V.A.; Nogueira, R.J. Antimicrobial Activity of Copaiba (Copaifera officinalis) and Pracaxi (Pentaclethra macroloba) Oils against Staphylococcus aureus: Importance in Compounding for Wound Care. Int. J. Pharm. Compd. 2016, 20, 58–62. [Google Scholar]
- Zapata, A.; Arcos, S.R. A Comparative Study of McFarland Turbidity Standards and the Densimat Photometer to Determine Bacterial Cell Density. Curr. Microbiol. 2015, 70, 907–909. [Google Scholar] [CrossRef]
- Wang, H.; Hao, L.; Wang, P.; Chen, M.; Jiang, S.; Jiang, S. Release kinetics and antibacterial activity of curcumin loaded zein fibers. Food Hydrocoll. 2017, 63, 437–446. [Google Scholar] [CrossRef]
- Malhotra, R.; Dhawan, B.; Garg, B.; Shankar, V.; Nag, T.C. A Comparison of Bacterial Adhesion and Biofilm Formation on Commonly Used Orthopaedic Metal Implant Meterials: An In vitro Study. Indian J. Orthop. 2019, 53, 148–153. [Google Scholar] [CrossRef]
- Lencova, S.; Syarcova, V.; Stiborova, H.; Demmerova, K.; Jencova, V.; Hozdova, K.; Zdenkova, K. Bacterial Biofilms on Polyamide Nanofibers: Factors Influencing Biofilm Formation and Evaluation. Appl. Mater. Interfaces 2021, 13, 2277–2288. [Google Scholar] [CrossRef]

Disclaimer/Publisher’s Note: The statements, opinions and data contained in all publications are solely those of the individual author(s) and contributor(s) and not of MDPI and/or the editor(s). MDPI and/or the editor(s) disclaim responsibility for any injury to people or property resulting from any ideas, methods, instructions or products referred to in the content. |
© 2023 by the authors. Licensee MDPI, Basel, Switzerland. This article is an open access article distributed under the terms and conditions of the Creative Commons Attribution (CC BY) license (https://creativecommons.org/licenses/by/4.0/).
Share and Cite
Pinto, M.F.; Quevedo, B.V.; Asami, J.; Komatsu, D.; Hausen, M.d.A.; Duek, E.A.d.R. Electrospun Membrane Based on Poly(L-co-D,L lactic acid) and Natural Rubber Containing Copaiba Oil Designed as a Dressing with Antimicrobial Properties. Antibiotics 2023, 12, 898. https://doi.org/10.3390/antibiotics12050898
Pinto MF, Quevedo BV, Asami J, Komatsu D, Hausen MdA, Duek EAdR. Electrospun Membrane Based on Poly(L-co-D,L lactic acid) and Natural Rubber Containing Copaiba Oil Designed as a Dressing with Antimicrobial Properties. Antibiotics. 2023; 12(5):898. https://doi.org/10.3390/antibiotics12050898
Chicago/Turabian StylePinto, Marcelo Formigoni, Bruna V. Quevedo, Jessica Asami, Daniel Komatsu, Moema de Alencar Hausen, and Eliana Aparecida de Rezende Duek. 2023. "Electrospun Membrane Based on Poly(L-co-D,L lactic acid) and Natural Rubber Containing Copaiba Oil Designed as a Dressing with Antimicrobial Properties" Antibiotics 12, no. 5: 898. https://doi.org/10.3390/antibiotics12050898
APA StylePinto, M. F., Quevedo, B. V., Asami, J., Komatsu, D., Hausen, M. d. A., & Duek, E. A. d. R. (2023). Electrospun Membrane Based on Poly(L-co-D,L lactic acid) and Natural Rubber Containing Copaiba Oil Designed as a Dressing with Antimicrobial Properties. Antibiotics, 12(5), 898. https://doi.org/10.3390/antibiotics12050898







